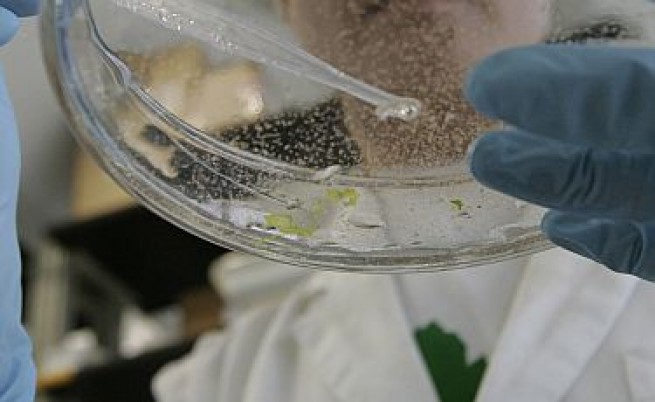
Връзка между Омега-3 и рак на простатата

З апазете спокойствие и опитайте омега-3. Мастните киселини, предлагани като хранителни добавки чрез капсули с рибено масло и за които се смята, че помагат за психическото и физическото благополучие, също биха могли да намалят агресията, според проучване от 2024 г.
Тези открития не са се появили от нищото: омега-3 мастните киселини преди това са били свързвани с предотвратяването на шизофрения, докато се смята, че агресията и антисоциалното поведение отчасти произтичат от липса на хранене. Това, което ядем, може да повлияе на химията на мозъка ни.
Изследователи от Университета на Пенсилвания надградиха по-ранни, по-малки проучвания за ефектите на добавките с омега-3 върху агресията. Техният мета-анализ разгледа 29 рандомизирани контролирани проучвания с общо 3918 участници.
Във всички проучвания е установен умерен, но забележим краткосрочен ефект, изразяващ се в намаление на агресията с до 28% при множество различни променливи (включително възраст, пол, медицинска диагноза и продължителност и дозировка на лечението).
A new tool for anger management?https://t.co/tI7EW2fmrc
— ScienceAlert (@ScienceAlert) November 3, 2025
„Мисля, че е дошло времето да се въведат добавки с омега-3 мастни киселини, за да се намали агресията, независимо дали обстановката е в общността, клиниката или системата на наказателното правосъдие“, каза неврокриминологът Адриан Рейн при публикуването на мета-анализа.
Проучванията, включени в проучването, проведени между 1996 и 2024 г., са продължили средно 16 седмици. Те са обхванали различни демографски групи, от деца на възраст 16 и по-малко години до възрастни хора на възраст между 50 и 60 години.
Нещо повече, намаляването на агресията включва както реактивна агресия (в отговор на провокация), така и проактивна агресия (поведение, планирано предварително). Преди това проучване не беше ясно дали омега-3 може да помогне с тези различни видове агресия.
Въпреки че ще са необходими по-мащабни проучвания за по-дълги периоди от време, за да се установи по-нататък тази връзка, това допринася за разбирането ни за това как хапчетата рибено масло и омега-3 мастните киселини в тях могат да бъдат полезни за мозъка.
„Най-малкото, родителите, които търсят лечение за агресивно дете, трябва да знаят, че в допълнение към всяко друго лечение, което детето им получава, една или две допълнителни порции риба всяка седмица също биха могли да помогнат“, каза Рейн.
Изследователите смятат, че нещо в начина, по който омега-3 намалява възпалението и поддържа жизненоважни мозъчни процеси, може да помага за регулиране на агресията. Все още има много въпроси без отговор, но екипът предполага, че има достатъчно доказателства, за да се проучи това по-задълбочено.
Добавете към това проучванията, които показват, че лекарствата, получени от рибено масло, могат да помогнат за намаляване на риска от фатални инфаркти, инсулти и други сърдечни проблеми, и изглежда има много предимства в добавянето на омега-3 към вашата диета.
„Омега-3 не е магическо лекарство, което ще реши напълно проблема с насилието в обществото. Но може ли да помогне? Въз основа на тези открития, ние твърдо вярваме, че може, и трябва да започнем да действаме въз основа на новите знания, които имаме“, каза Рейн.